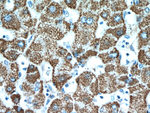
HADH Antibody in Immunohistochemistry (Paraffin) (IHC (P))

Search
Proteintech
HADH Polyclonal Antibody
{{$productOrderCtrl.translations['antibody.pdp.commerceCard.promotion.promotions']}}
{{$productOrderCtrl.translations['antibody.pdp.commerceCard.promotion.viewpromo']}}
{{$productOrderCtrl.translations['antibody.pdp.commerceCard.promotion.promocode']}}: {{promo.promoCode}} {{promo.promoTitle}} {{promo.promoDescription}}. {{$productOrderCtrl.translations['antibody.pdp.commerceCard.promotion.learnmore']}}
产品信息
19828-1-AP
种属反应
已发表种属
宿主/亚型
分类
类型
抗原
偶联物
形式
浓度
规格
纯化类型
保存液
内含物
保存条件
运输条件
产品详细信息
Immunogen sequence: MAFVTRQFM RSVSSSSTAS ASAKKIIVKH VTVIGGGLMG AGIAQVAAAT GHTVVLVDQT EDILAKSKKG IEESLRKVAK KKFAENPKAG DEFVEKTLST IATSTDAASV VHSTDLVVEA IVENLKVKNE LFKRLDKFAA EHTIFASNTS SLQITSIANA TTRQDRFAGL HFFNPVPVMK LVEVIKTPMT SQKTFESLVD FSKALGKHPV SCKDTPGFIV NRLLVPYLME AIRLYERGDA SKEDIDTAMK LGAGYPMGPF ELLDYVGLDT TKFIVDGWHE MDAENPLHQP SPSLNKLVAE NKFGKKTGEG FYKYK (1-314 aa encoded by BC000306)
靶标信息
This gene is a member of the 3-hydroxyacyl-CoA dehydrogenase gene family. The encoded protein functions in the mitochondrial matrix to catalyze the oxidation of straight-chain 3-hydroxyacyl-CoAs as part of the beta-oxidation pathway. Its enzymatic activity is highest with medium-chain-length fatty acids. Mutations in this gene cause one form of familial hyperinsulinemic hypoglycemia. The human genome contains a related pseudogene of this gene on chromosome 15.
仅用于科研。不用于诊断过程。未经明确授权不得转售。
生物信息学
蛋白别名: broad specificity for acyl chain length; HCDH; Hydroxyacyl-coenzyme A dehydrogenase, mitochondrial; hydroxylacyl-Coenzyme A dehydrogenase short chain; hydroxylacyl-Coenzyme A dehydrogenase, short chain; hydroxylacyl-Coenzyme A dehydrogenase-dehydrogenase; L-3-hydroxyacyl-Coenzyme A dehydrogenase, short chain; M/SCHAD; medium and short chain L-3-hydroxyacyl-coenzyme A dehydrogenase; Medium and short-chain L-3-hydroxyacyl-coenzyme A dehydrogenase; MGC8392; short chain 3-hydroxyacyl-CoA dehydrogenase; Short-chain 3-hydroxyacyl-CoA dehydrogenase; testis secretory sperm-binding protein Li 203a; unnamed protein product
基因别名: AA409008; AU019341; AW742602; HAD; HAD1; HADH; HADH1; HADHSC; HCDH; HHF4; MSCHAD; SCHAD
UniProt ID: (Human) Q16836, (Mouse) Q61425, (Rat) Q9WVK7
Entrez Gene ID: (Human) 3033, (Mouse) 15107, (Rat) 113965